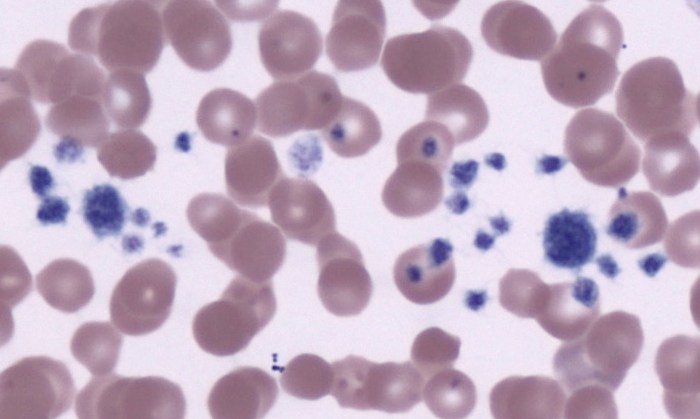
Platelets 15 (Feline 6)
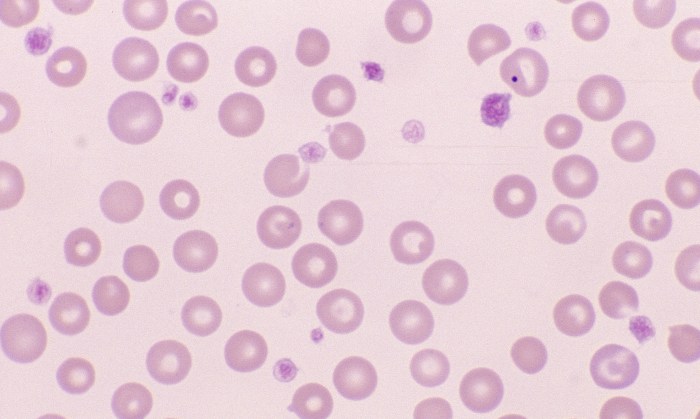
Platelets 1 (Canine 1 - Macrocytic Normochromic Anemia)
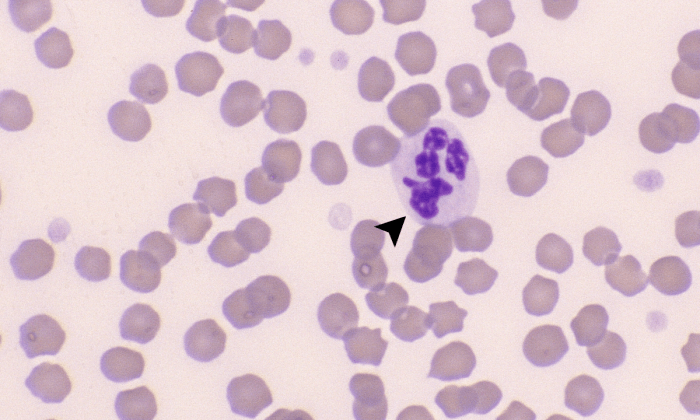
Platelets 6 (Equine 1) ARROWS
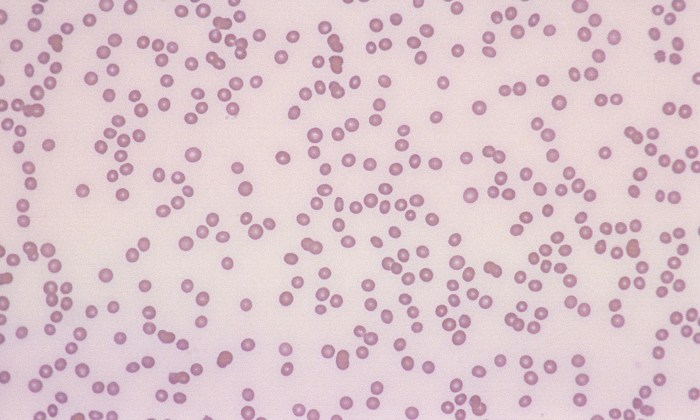
Platelets 10 (Canine 4) - Thrombocytopenia
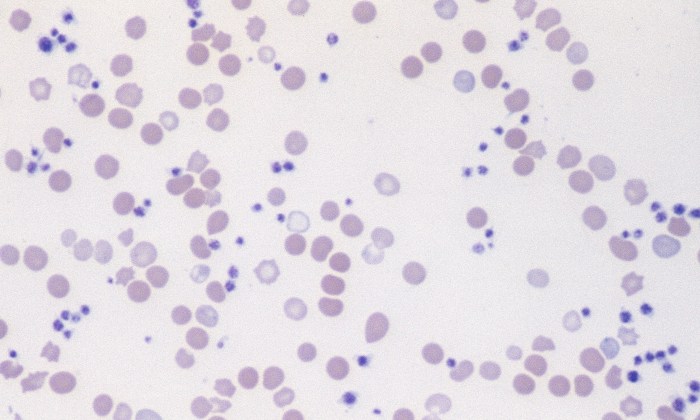
Platelets 12 (Canine 5 - Iron Deficiency) - Thrombocytosis
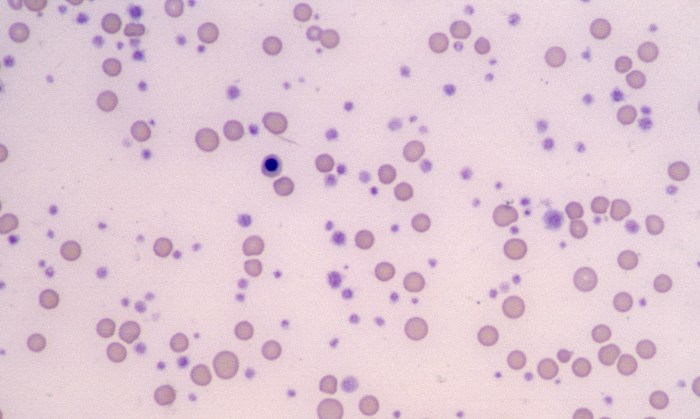
Platelets 13 (Feline 4 - Megakaryocytic Leukemia) - Thrombocytosis

Normal Platelets
Morphology: platelets are small anucleate cells with round to oval shape and small pink or red cytoplasmic granules. Normal platelets are smaller than red blood cells. Canine platelets are moderately variable in size. Feline platelets are markedly variable in size (giant platelets are frequently observed in healthy cats) and tend to activate and clump readily. Bovine platelets are moderately variable in size, and cattle have relatively high platelet counts. Equine platelets are uniform in size and shape with pale granules that may be difficult to see, and horses often have lower platelet counts than other species.
Platelet count: can be estimated from blood smears by counting the average number of platelets per 100x oil immersion field in the monolayer (count 10 fields and average the results). Estimated platelet count (platelets/µL) = average count in 10 fields x 20,000.
Clinical relevance: platelets play an important role in primary hemostasis. Thrombocytopenia (↓ platelets in peripheral blood) may result from a variety of causes: artifact (clumping during collection, iatrogenic hemodilution), congenital (inherited macrothrombocytopenia), decreased platelet production in bone marrow (drugs, neoplasia, infections), increased consumption of platelets in coagulation (DIC), increased destruction of platelets (primary or secondary immune-mediated thrombocytopenia), and loss of platelets (acute massive hemorrhage). Note that thrombocytopenia is very rare in cats and cattle. Thrombocytosis (↑ platelets in peripheral blood) may be physiologic (splenic contraction), reactive (neoplasia, chronic inflammation, immune-mediated diseases, trauma/fractures, iron deficiency), or secondary to drugs (corticosteroids, vincristine). Young animals (especially calves and foals) may have platelet counts higher than adult reference intervals.

1 Comment »